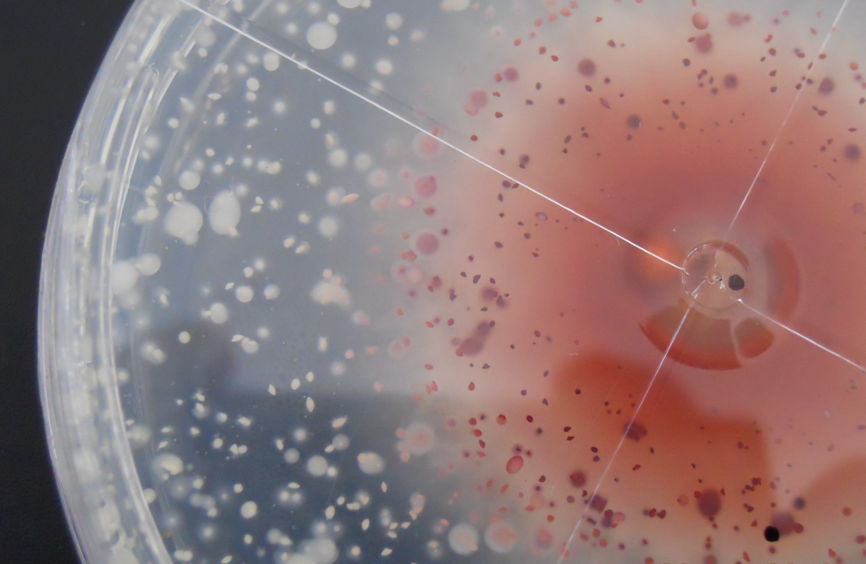
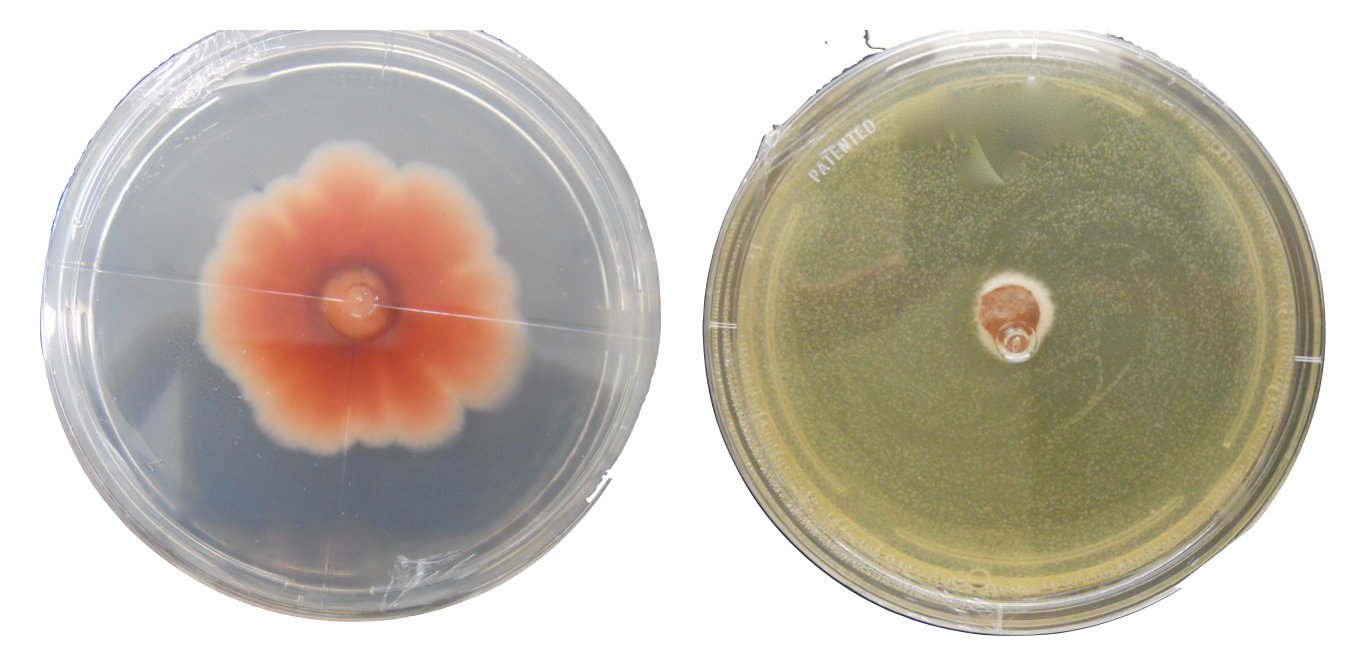
Control de patógenos Fusarium, Sclerotinia y Alternaria in vitro con Fungi Q

Soluciones biológicas para la protección y nutrición de cultivos
Productos desarrollados para apoyar programas de manejo agrícola mediante microorganismos benéficos y extractos naturales.
Nuestros Productos

Certificaciones y Permisos
Certificados para agricutlura orgánica y registro COFEPRIS
Autorizados para ser utilizados en agricultura orgánica y con registros COFEPRIS en México.
Investigación y Desarrollo
Productos basados en años de investigación
Validamos nuestros resultados en laboratorio con la intención de garantizar resultados en campo

Nuestra Empresa
Empresa Mexicana con mas de 30 años de experiencia
Desde nuestros inicios hemos trabajado cercanos a los productores y entendemos las necesidades en campo. Es por esto que nos preocupamos por fomentar un campo más sustentable y rentable para el agricultor.
Algunos de nuestros resultados Caso de Estudio - Control de Fusarium spp en Laboratorio
Dos cajas Petri son inoculadas con el hongo Fusarium spp. En la izquierda (testigo), el hongo Fusarium spp crece de forma natural. En la derecha se agrega Fungi Q para validar control.

Testigo de Fusarium spp
Se observa como el hongo (mancha roja) se expande despues de 48 horas
Fungi Q contra Fusarium spp
Se observa como el hongo se mantiene en el centro sin crecimiento. Las bacterias de Fungi Q se expanden por la caja Petri
Suscríbete a nuestro newsletter
Mandaremos promociones, artículos de interes y mucho más!